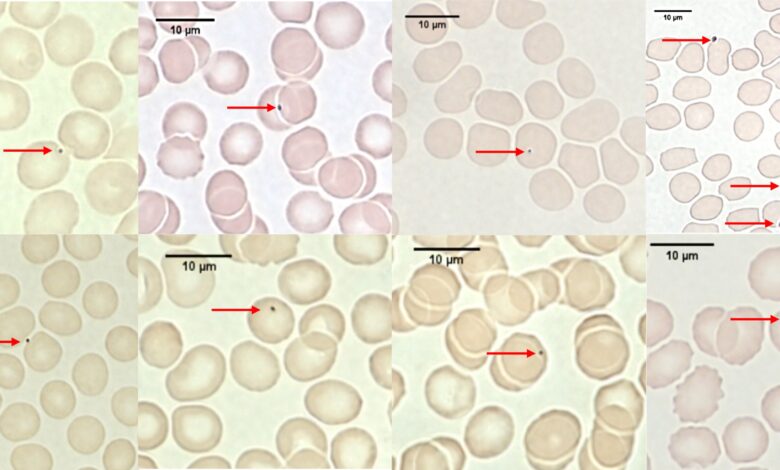

Air pollution particles discovered hitching a ride around the body on red blood cells
A groundbreaking study has revealed that tiny particles of air pollution can attach themselves to red blood cells, allowing them to circulate throughout the body. These pollution particles, which are commonly found in vehicle exhausts, brake, and tire wear, pose a significant health risk as they have been linked to various diseases when present in organs like the brain and heart.
The research, published in ERJ Open Research, was conducted by Professor Jonathan Grigg, Dr. Norrice Liu, and their team at Queen Mary University of London, UK. The study involved 12 adult volunteers who were exposed to air pollution particles while spending time near a busy London road. Blood samples were taken from the volunteers before and after exposure, revealing an increase in pollution particles adhering to their red blood cells after being by the roadside.
The findings showed that levels of particle air pollution by the roadside were significantly higher compared to the office building where the volunteers initially spent time. Despite only a small proportion of red blood cells carrying particles after exposure, the researchers estimated that around 80 million red blood cells in the human body could be transporting particles after standing near a main road for an hour.
Interestingly, when the volunteers repeated the experiment wearing FFP2 face masks, the amount of pollution particles stuck to their red blood cells did not increase. This discovery marks the first study to demonstrate that wearing an FFP2 mask can reduce the dose of inhaled pollution particles in humans.
Further experiments conducted in the lab confirmed that pollution particles easily attach to both human and mouse red blood cells. Analysis of the particles found on the volunteer’s blood cells revealed the presence of various metals known to be produced by vehicle exhausts, brake, and tire wear. These particles, measuring 2.5 micrometers or smaller, correspond to the PM2.5 measure used to monitor air pollution.
Professor Grigg highlighted the significance of the findings, stating that air pollution particles can hijack red blood cells, allowing them to travel throughout the body and potentially infiltrate different organs. The study provides a simple method to measure the amount of pollution entering the body and emphasizes the importance of protective measures like face masks in reducing exposure to harmful particles.
Professor Ane Johannessen, an expert in epidemiology and environment, emphasized the need for laws to lower air pollution levels and reduce the health risks associated with exposure. The study’s findings shed light on how dangerous particles can infiltrate every part of the body via the bloodstream, highlighting the importance of protective measures and environmental regulations to safeguard public health.





